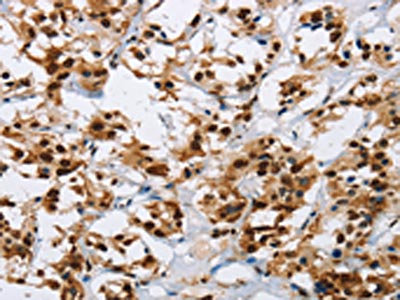

IL17C Antibody
-
中文名稱:IL17C兔多克隆抗體
-
貨號:CSB-PA959846
-
規格:¥1100
-
圖片:
-
The image on the left is immunohistochemistry of paraffin-embedded Human thyroid cancer tissue using CSB-PA959846(IL17C Antibody) at dilution 1/50, on the right is treated with synthetic peptide. (Original magnification: ×200)
-
Gel: 10%SDS-PAGE, Lysate: 40 μg, Lane 1-4: A549 cells, K562 cells, Raji cells, human fetal intestine tissue, Primary antibody: CSB-PA959846(IL17C Antibody) at dilution 1/300, Secondary antibody: Goat anti rabbit IgG at 1/8000 dilution, Exposure time: 20 seconds
-
-
其他:
產品詳情
-
Uniprot No.:
-
基因名:
-
別名:CX2 antibody; Cytokine CX2 antibody; IL 17C antibody; IL 21 antibody; IL-17C antibody; IL17C antibody; IL17C_HUMAN antibody; Interleukin 17C antibody; Interleukin-17C antibody; MGC126884 antibody; MGC138401 antibody
-
宿主:Rabbit
-
反應種屬:Human
-
免疫原:Synthetic peptide of Human IL17C
-
免疫原種屬:Homo sapiens (Human)
-
標記方式:Non-conjugated
-
抗體亞型:IgG
-
純化方式:Antigen affinity purification
-
濃度:It differs from different batches. Please contact us to confirm it.
-
保存緩沖液:-20°C, pH7.4 PBS, 0.05% NaN3, 40% Glycerol
-
產品提供形式:Liquid
-
應用范圍:ELISA,WB,IHC
-
推薦稀釋比:
Application Recommended Dilution ELISA 1:2000-1:5000 WB 1:500-1:2000 IHC 1:50-1:200 -
Protocols:
-
儲存條件:Upon receipt, store at -20°C or -80°C. Avoid repeated freeze.
-
貨期:Basically, we can dispatch the products out in 1-3 working days after receiving your orders. Delivery time maybe differs from different purchasing way or location, please kindly consult your local distributors for specific delivery time.
-
用途:For Research Use Only. Not for use in diagnostic or therapeutic procedures.
相關產品
靶點詳情
-
功能:Cytokine that plays a crucial role in innate immunity of the epithelium, including to intestinal bacterial pathogens, in an autocrine manner. Stimulates the production of antibacterial peptides and proinflammatory molecules for host defense by signaling through the NF-kappa-B and MAPK pathways. Acts synergically with IL22 in inducing the expression of antibacterial peptides, including S100A8, S100A9, REG3A and REG3G. Synergy is also observed with TNF and IL1B in inducing DEFB2 from keratinocytes. Depending on the type of insult, may have both protective and pathogenic properties, either by maintaining epithelial homeostasis after an inflammatory challenge or by promoting inflammatory phenotype. Enhanced IL17C/IL17RE signaling may also lead to greater susceptibility to autoimmune diseases.
-
基因功能參考文獻:
- Inflammatory cell expression of IL-9 and IL-17C were increased in chronic rhinosinusitis, particularly with allergy and asthma. These interleukins may contribute to the pathogenesis of chronic rhinosinusitis with nasal polyps as well as atopy and may serve as therapeutic targets for disease management PMID: 26989880
- Helicobacter pylori infection was associated with a significant increase in IL-17C expression in gastric mucosa. The role of IL-17C in the pathogenesis of H. pylori-induced diseases remains to be determined. PMID: 28739826
- Data indicate that epithelial IL-17C promotes neutrophilic inflammation in the tumor microenvironment and suggest that IL-17C links a pathologic microbiota, as present in COPD patients, with enhanced tumor growth. PMID: 28346430
- CpG methylation is reduced in gingival biopsies of patients with periodontitis PMID: 26472015
- Those carrying rs3748067 CC genotype and C allele had a significantly increased risk for the development of gastric cancer PMID: 25012243
- IL-17C is an essential epithelial cell-derived cytokine. PMID: 23944933
- Our study provides evidence that Staphylococcus aureus activates NOD2 in keratinocytes, resulting in an increased expression of IL-17C, a mechanism that may be dysregulated in atopic dermatitis. PMID: 23892590
- Interleukin-17C is present in the tissue around aseptic loosened implants. PMID: 23474800
- IL-17C is involved in the innate immune response of respiratory epithelial cells and is suppressed by cigarette smoke. PMID: 23221046
- Data suggest that activation of TLR5 upregulates IL17C expression in cells from intestinal mucosa and colonic adenocarcinoma; IL17C expression is upregulated in intestinal mucosa cells from patients with ulcerative colitis compared with normal cells. PMID: 22994872
- Keratinocyte overexpression of IL-17C promotes psoriasiform skin inflammation. PMID: 23359500
- In our pilot study, we discovered significant changes in methylation patterns of genes IL-7, IL-13, IL-17C and TYK2 between henodialysis patients and healthy subjects PMID: 22506826
- IL-17C is an essential autocrine cytokine that regulates innate epithelial immune responses. PMID: 21993848
- activation of NF-kappaB (p65/p50) is crucial for the TNFalpha-induced stimulation of IL-17C expression in human keratinocytes PMID: 21628458
- expressed in multiple sclerosis brain lesions PMID: 11984595
顯示更多
收起更多
-
亞細胞定位:Secreted.
-
蛋白家族:IL-17 family
-
數據庫鏈接:
Most popular with customers
-
-
YWHAB Recombinant Monoclonal Antibody
Applications: ELISA, WB, IHC, IF, FC
Species Reactivity: Human, Mouse, Rat
-
Phospho-YAP1 (S127) Recombinant Monoclonal Antibody
Applications: ELISA, WB, IHC
Species Reactivity: Human
-
-
-
-
-